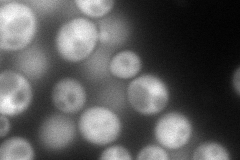
YJR024C
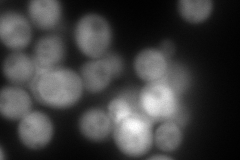
YJR024C

View description
5'-methylthioribulose-1-phosphate dehydratase; acts in the methionine salvage pathway; potential Smt3p sumoylation substrate; expression downregulated by caspofungin and deletion mutant is caspofungin resistant
Localization:
Intensity:
Fold change:
Significance:
-
C’ GFP library in SD

cytosol20.85 -
N' NOP1pr-GFP in SD
cytosol187.43 -
N' TEF2pr-mCherry in SD
cytosol288.726 -
N' NATIVEpr-GFP in SD

cytosol34.2681 -
N' TEF2pr-VC and Cyto-VN in SD

cytosol50.2694 -
C’ GFP library in SD+DTT

cytosol24.031.15No -
C’ GFP library in SD+H2O2

cytosol17.770.85No -
C’ GFP library in Starvation Media

cytosol23.181.11No -
C’ GFP library on the background of Pup2-DaMP

cytosol -
C’ GFP library on the background of CCT mutant

cytosol17.85240.8559No
